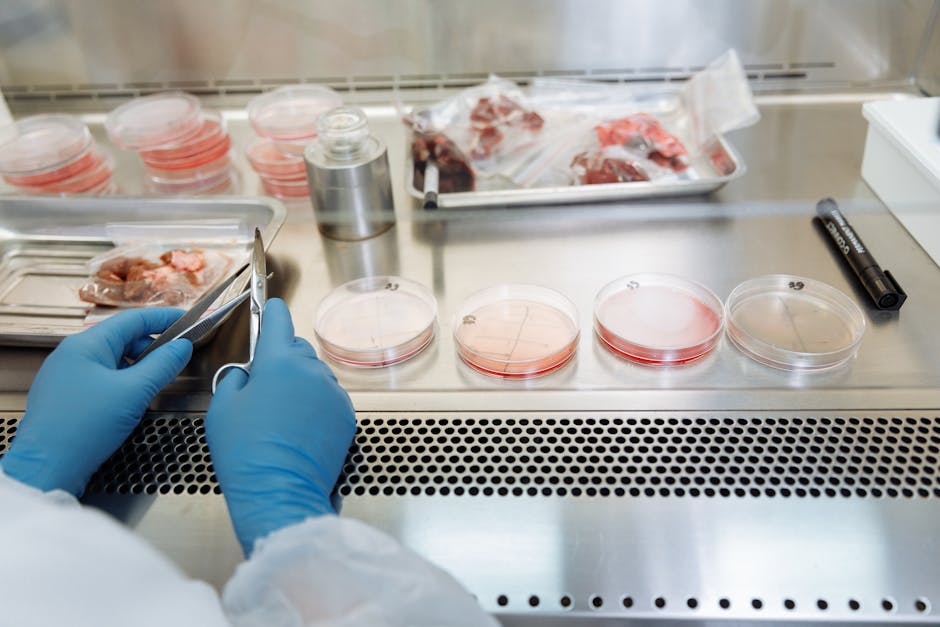

Technicien / Technicienne de production animale
Aussi appelé : Technicien / Technicienne de la transplantation d'embryons animaux, Technicien / Technicienne avicole, Technicien / Technicienne bâtiments d'élevage, Technicien / Technicienne bovin et 9 autres
Le Technicien de production animale assiste les éleveurs et maintient et améliore la qualité de la production animale.
Supervise et optimise les processus de production animale pour garantir la qualité et la quantité des produits
Contrôle la santé et le bien-être des animaux, en veillant à leur alimentation et à leur environnement
Gère la reproduction des animaux et suit le développement des jeunes
Maintient à jour les registres de production et de santé animale conformément aux réglementations
Collabore avec des vétérinaires pour prévenir et traiter les maladies animales
Participe à la recherche et à l'implémentation de nouvelles techniques pour améliorer l'efficacité de l'élevage
Offres publiées
213
postes ouverts sur France Travail · 22 avril 2026
En recherche d'emploi
190
personnes cherchant un poste dans ce métier · T1 2025
Retour à l'emploi
47 %
retrouvent un emploi dans le trimestre · T1 2025
🛠️ Compétences techniques
Référentiel ROME 4.0ROME 4.0Répertoire Opérationnel des Métiers et des Emplois. Référentiel officiel de France Travail qui recense et décrit environ 11 000 appellations de métiers, regroupées en 531 fiches. La version 4.0 (2022) intègre les compétences transversales et les métiers émergents.Source officielle :France Travail
⚙️ Gestion
- Planifier les vaccinations des animaux
- Gérer l'alimentation des animaux selon leur espèce
- Organiser les rotations des pâturages
🎯 Pilotage
- Réaliser la reproduction artificielle d'une espèce animale
- Appliquer les protocoles de sécurité sanitaire
🔍 Analyse
- Identifier un animal par marquage
✍️ Communication
- Documenter les procédures et les résultats d'élevage
▸ Autre
- Evaluer le comportement et l'état de santé d'un animal
- Préparer les animaux et procéder à l'insémination
- Surveiller l'état de gestation d'un animal
- Manipuler des animaux
- Entretenir un élevage animal
- Répartir les animaux dans des locaux d'élevage ou en plein air
- Transformer un produit de l'élevage
- Respecter les règles de Qualité, Hygiène, Sécurité, Santé et Environnement (QHSSE)
🧩 Qualités professionnelles
Savoir-être — ROME 4.0
- 📋Organiser son travail selon les priorités et les objectifs
- ✨Etre force de proposition
- 🤝Avoir l'esprit d'équipe
📚 Domaines de connaissance
Savoirs théoriques — ROME 4.0
- Méthodes d'élevage
- Bien-être animal
- Pathologies animales
- Nutrition animale
- Techniques d'approche et de manipulation des animaux
- Techniques de reproduction animale
- Techniques d'identification animale
- Gestion des pâturages
- Techniques de gestion de l'eau pour l'élevage
- Production animale
🎓 Accès à l'emploi
Diplômes reconnus — référentiel ROME 4.0ROME 4.0Répertoire Opérationnel des Métiers et des Emplois. Référentiel officiel de France Travail qui recense et décrit environ 11 000 appellations de métiers, regroupées en 531 fiches. La version 4.0 (2022) intègre les compétences transversales et les métiers émergents.Source officielle :France Travail
Cet emploi est accessible avec une formation de niveau Bac à Bac +3 en agriculture, élevage et productions Animales.
Bac+3 / Bac+4 — Licence / Bachelor
- Licence pro mention productions animales
Autres diplômes reconnus
- Certificat de spécialisation conduite d'un élevage ovin viande mention agriculture biologique
- Certificat de spécialisation conduite d'un élevage caprin
- Certificat de spécialisation conduite d'un élevage porcin mention agriculture biologique
- Certificat de spécialisation conduite d'un élevage caprin mention agriculture biologique
- Certificat de spécialisation conduite d'un élevage bovin viande mention transformation de la viande
- Certificat de spécialisation conduite d'un élevage ovin viande mention transformation de la viande
- Certificat de spécialisation conduite d'un élevage porcin mention transformation de la viande
- Certificat de spécialisation conduite d'un élevage bovin viande
- Certificat de spécialisation conduite d'un élevage porcin
- Certificat de spécialisation conduite d'un élevage ovin viande
- Certificat de spécialisation conduite d'un élevage bovin lait
- Certificat de spécialisation conduite d'un élevage bovin lait mention agriculture biologique
- Certificat de spécialisation conduite d'un élevage bovin viande mention agriculture biologique
- BTSA analyse, conduite et stratégie de l'entreprise agricole
- BTSA productions animales
💡 Pas de diplôme ? La VAEVAE — Validation des Acquis de l'ExpérienceDispositif permettant d'obtenir un diplôme ou titre professionnel (inscrit au RNCP) en faisant reconnaître ses compétences acquises par l'expérience professionnelle, sans suivre de formation. Ouvert à toute personne justifiant d'au moins 1 an d'expérience.Source officielle :Ministère du Travail permet de valider ce métier par l'expérience.
🔀 Métiers proches
Passerelles issues du référentiel ROME 4.0ROME 4.0Répertoire Opérationnel des Métiers et des Emplois. Référentiel officiel de France Travail qui recense et décrit environ 11 000 appellations de métiers, regroupées en 531 fiches. La version 4.0 (2022) intègre les compétences transversales et les métiers émergents.Source officielle :France Travail — utile pour une reconversion
Agriculture & Agroalimentaire— même secteur
Hôtellerie, Restauration & Tourisme
Transport & Logistique
Commerce & Vente
Offres en ce moment
213 offres au totalListe des 100 dernières offres publiées dans les 90 derniers jours · ingéré le 22 avril 2026 à 20h31
- CDI
Technicien animalier (H/F)
Paris 14 - CDI
EXPERT COMPTABLE ASSOCIE (H/F)
Pau - CDI
Conseiller nutritionniste caprin (F/H) - CHANGE (H/F)
Changé - CDI
RESPONSABLE QHSE AGROALIMENTAIRE (F/H) SPÉCIALISATION NEMS DE PORC (H/F)
Stains - CDI
Technicien (H/F) - Anglet
Bayonne - Profession
Consultant en vae (h/f) - h/f - Bergerac
Bergerac - Intérim 1M
EMPLOYE EBOURGEONNAGE (H/F)
Londe - Intérim 60J
TECHNICIEN AISSAINISSEMENT (F/H) (H/F)
Saint - CDI
TECHINICIEN MATÉRIEL D'ELEVAGE (F/H) (H/F)
Toul - CDD 12M
Alternance - Equipier polyvalent (CAP) - H/F
Faches
🦺 Risque d'accident du travail
Secteur Agriculture, sylviculture et pêche · pas spécifique au métier de Technicien / Technicienne de production animale
Très faible
< 5
Faible
5–14
Modéré
15–29
Élevé
30–49
Très élevé
≥ 50
Taux de gravité
1.235
journées d'arrêt pour 1 000 heures travaillées
Ces chiffres concernent l'ensemble du secteur Agriculture, sylviculture et pêche, pas uniquement le métier de Technicien / Technicienne de production animale. Le risque réel dépend du poste, de l'entreprise et des équipements.